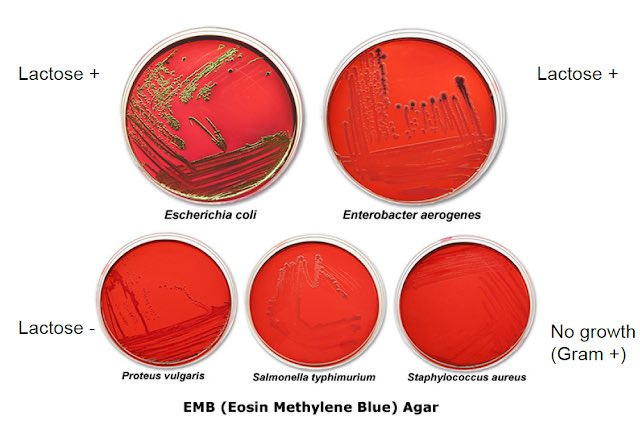

Escherichia coli d
Escherichia coli d 105 фото
Турецкие футболки интернет магазин
Социальный фонд рязань московское шоссе
Погода бишкеке часовой
Специалист по связям с общественностью код
Замок 3 логика игра логика слова
Вес листа кроношпан
Институт заочное обучение магистратуры
Выгодная мобильная сеть
Хонда 2000 мотоцикл
Большой займ с плохой кредитной историей